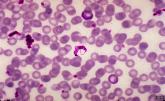

S
STAINING PROTOCOLS (N-terminal sequencing)
IN GEL STAINING (FOR IN-GEL DIGEST)
For all steps to avoid keratin contamination wear rinsed gloves, be in as dust-free environment as
possible, use electrophoresis, staining and destaining reagents and trays that are clean and not general
community property.
Run SDS-PAGE gel under your normal conditions.
Stain with .05% Coomassie Blue (G or R) in 5% acetic acid, 10% methanol for 15-30 min (or until you can
see your bands). Other stains such as colloidal coomassie, Pierce’s coomassie stains can also be used.
If necessary certain silver stains can be used as long as they are mass spec compatible.
Destain with 5% acetic acid, 10% methanol (until band is easily distinguished from background) or destain
as recommended by the stain manufacturer. Avoid destaining too long – not overnight. Rinse for 15 min
in deionized water. Gels can be stored in the refrigerator until ready to cut the bands.
Cut out bands with clean scalpel blade and put in microfuge tube; also you can include in a separate tube
an equal amount of gel with no protein as a control (optional).
Store at -20o or -80°C.
PVDF STAINING (FOR N-TERMINAL SEQUENCING)
Run SDS-PAGE gel. Use a gel poured at least 24hr prior to running and include 0.1mM thioglycolate as a
scavenger in the upper running buffer; these 2 precautions can help to prevent N-terminal blockage
during electrophoresis.
Electroblot to a PVDF membrane (TRIS-Glycine or CAPS buffer) at RT:
25mM TRIS, 192mM glycine, 10% MeOH, pH 8.3 - ~ 300mA for 1-4hr
10mM CAPS, 10% MeOH, pH 11 - ~300-500mA for 30-60 min
Rinse with deionized water for 2-5 min
Stain with .05% Coomassie Blue in 1% acetic acid, 50% methanol for a few min.
Destain in 50% methanol until background is pale blue (5-15 min).
Rinse for 5-10 min in deionized water.
Cut out the band with a clean scalpel blade, air-dry and put in microfuge tube. Can be stored at RT.
Freeze if it will be for an extended period of time.
STAINING PROTOCOLS (N-terminal sequencing)
IN GEL STAINING (FOR IN-GEL DIGEST)
For all steps to avoid keratin contamination wear rinsed gloves, be in as dust-free environment as
possible, use electrophoresis, staining and destaining reagents and trays that are clean and not general
community property.
Run SDS-PAGE gel under your normal conditions.
Stain with .05% Coomassie Blue (G or R) in 5% acetic acid, 10% methanol for 15-30 min (or until you can
see your bands). Other stains such as colloidal coomassie, Pierce’s coomassie stains can also be used.
If necessary certain silver stains can be used as long as they are mass spec compatible.
Destain with 5% acetic acid, 10% methanol (until band is easily distinguished from background) or destain
as recommended by the stain manufacturer. Avoid destaining too long – not overnight. Rinse for 15 min
in deionized water. Gels can be stored in the refrigerator until ready to cut the bands.
Cut out bands with clean scalpel blade and put in microfuge tube; also you can include in a separate tube
an equal amount of gel with no protein as a control (optional).
Store at -20o or -80°C.
PVDF STAINING (FOR N-TERMINAL SEQUENCING)
Run SDS-PAGE gel. Use a gel poured at least 24hr prior to running and include 0.1mM thioglycolate as a
scavenger in the upper running buffer; these 2 precautions can help to prevent N-terminal blockage
during electrophoresis.
Electroblot to a PVDF membrane (TRIS-Glycine or CAPS buffer) at RT:
25mM TRIS, 192mM glycine, 10% MeOH, pH 8.3 - ~ 300mA for 1-4hr
10mM CAPS, 10% MeOH, pH 11 - ~300-500mA for 30-60 min
Rinse with deionized water for 2-5 min
Stain with .05% Coomassie Blue in 1% acetic acid, 50% methanol for a few min.
Destain in 50% methanol until background is pale blue (5-15 min).
Rinse for 5-10 min in deionized water.
Cut out the band with a clean scalpel blade, air-dry and put in microfuge tube. Can be stored at RT.
Freeze if it will be for an extended period of time.
T
SOC Media (for Heat Shock/transformation)
0.5 % Yeast extract 0.2 g
2% Tryptone 0.8 g
10 mM NaCl 0.4 ml (1 M)
2.5 mM KCL 200 µl (0.5 M)
10 mM MgCl2 0.4 ml (1 M)
10 mM MgSO4 0.4 ml (1 M or 1 g)
20 mM Glucose 0.14 g
QS to 40 ml with dH2O; Sterile filter
0.5 % Yeast extract 0.2 g
2% Tryptone 0.8 g
10 mM NaCl 0.4 ml (1 M)
2.5 mM KCL 200 µl (0.5 M)
10 mM MgCl2 0.4 ml (1 M)
10 mM MgSO4 0.4 ml (1 M or 1 g)
20 mM Glucose 0.14 g
QS to 40 ml with dH2O; Sterile filter
SSC (20X)
175.3 g NaCl
88.2 g Na citrate
add 800 ml H2O, pH to 7.0 with
NaOH.
QS to 1 L.
Autoclave.
175.3 g NaCl
88.2 g Na citrate
add 800 ml H2O, pH to 7.0 with
NaOH.
QS to 1 L.
Autoclave.
SSPEC (20X)
-175.3 g NaCl
-27.6 g NaH2PO4-H2O
-7.4 g EDTA (0.02 M EDTA final
concentration (add 40 ml of 0.5 M
EDTA).
-800 ml H2O.
Adjust pH to 7.4 with NaOH.
QS to 1 L
-175.3 g NaCl
-27.6 g NaH2PO4-H2O
-7.4 g EDTA (0.02 M EDTA final
concentration (add 40 ml of 0.5 M
EDTA).
-800 ml H2O.
Adjust pH to 7.4 with NaOH.
QS to 1 L
Stripping Southern Blot
-Incubate blot in boiling solution
of 0.5% (w/v) SDS with shaking
and allow to return to RT.
-Re probe.
-Use 7.5 ml of 20% SDS in 300
ml H2O.
-Incubate blot in boiling solution
of 0.5% (w/v) SDS with shaking
and allow to return to RT.
-Re probe.
-Use 7.5 ml of 20% SDS in 300
ml H2O.
STE
0.1 M NaCl 10 ml 5 M NaCl
10 mM Tris-HCL (pH 8.0) 5 ml 1 M Tris-HCL
1 mM EDTA (pH 8.0) 1 ml 0.5 M EDTA
0.1 M NaCl 10 ml 5 M NaCl
10 mM Tris-HCL (pH 8.0) 5 ml 1 M Tris-HCL
1 mM EDTA (pH 8.0) 1 ml 0.5 M EDTA
SDS (20%)
Wear mask to prevent inhalation.
50 g SDS (Lauryl sulfate)
-Add 250 ml H2O.
-Stir and heat to dissolve.
Wear mask to prevent inhalation.
50 g SDS (Lauryl sulfate)
-Add 250 ml H2O.
-Stir and heat to dissolve.
Super Broth (2X-YT)
-for the growth of M15 cells.
16 g Bacto-tryptone
10 g Bacto-yeast extract
5 g NaCl
1 L H2O, autoclave.
-for the growth of M15 cells.
16 g Bacto-tryptone
10 g Bacto-yeast extract
5 g NaCl
1 L H2O, autoclave.
Strip Buffer (4X) Nickle Column
100 ml 250ml
400 mM EDTA (pH 8.0 ) 80 ml (0.5 M) 200 ml
2 M NaCl 11.7 g 29.25 g
80 mM Tris-HCL (pH 8.0) 8 ml (1 M) 20 ml
H2O 12 ml 30 ml
Filter, store @4°C.
100 ml 250ml
400 mM EDTA (pH 8.0 ) 80 ml (0.5 M) 200 ml
2 M NaCl 11.7 g 29.25 g
80 mM Tris-HCL (pH 8.0) 8 ml (1 M) 20 ml
H2O 12 ml 30 ml
Filter, store @4°C.
NaCl (5 M)
292.2 g NaCl + 800 ml H2O; stir and heat
dissolve if necessary, QS to 1 L.
292.2 g NaCl + 800 ml H2O; stir and heat
dissolve if necessary, QS to 1 L.
Sample Buffer (4X, SDS-PAGE GELS)
Reagent Percent Amount
Reagent Amount
Tris-HCL (MW 157.6) 3.152 g
(Dissolve in 45 ml water, pH to 6.8, QS to 50 ml)
SDS 8.0 g
Glycerol 40 ml
Bromphenol Blue 0.1 ml
DTT 0.62 g (40
mM)
QS to 100 ml. Aliquot into 1 ml epi tubes.
For non denaturing omit adding SDS.
Reagent Percent Amount
Reagent Amount
Tris-HCL (MW 157.6) 3.152 g
(Dissolve in 45 ml water, pH to 6.8, QS to 50 ml)
SDS 8.0 g
Glycerol 40 ml
Bromphenol Blue 0.1 ml
DTT 0.62 g (40
mM)
QS to 100 ml. Aliquot into 1 ml epi tubes.
For non denaturing omit adding SDS.
Tris (Tris Base or Trizma)
1 M- 121.1 g Tris Base in 800 ml
H2O. Adjust pH to desired value
using HCL. QS to 1 L.
0.2 M-24.22 g Tris Base in 800 ml
H2O. pH to 7.5 and QS to 1 L.
1 M- 121.1 g Tris Base in 800 ml
H2O. Adjust pH to desired value
using HCL. QS to 1 L.
0.2 M-24.22 g Tris Base in 800 ml
H2O. pH to 7.5 and QS to 1 L.
Tris HCL (1 M)
156.6 F.W.
For 500 ml; 78.8 g Tris HCL in
500 ml H2O.
156.6 F.W.
For 500 ml; 78.8 g Tris HCL in
500 ml H2O.
Transformation-see Heat
Shock.
Shock.
Tetracyclin (TET)
3 mg/ml n EtOH; E/E 20 min
to disolve.
Use 1 µl/ml.
TET Plates
-30 g TSB + 15 g Agar + 1 L
H2O.
-Autoclave
-Allow to cool until
erlenmeyer flask cool
enough to pick up with
bare hands and then add 1
ml of TET (3 mg/ml).
3 mg/ml n EtOH; E/E 20 min
to disolve.
Use 1 µl/ml.
TET Plates
-30 g TSB + 15 g Agar + 1 L
H2O.
-Autoclave
-Allow to cool until
erlenmeyer flask cool
enough to pick up with
bare hands and then add 1
ml of TET (3 mg/ml).
T cell Stimulation/Proliferation (BAT2.2 cells)
-Remove 5,000,000 BATs (1 freezing vial).
-Thaw at 37°C (H2O bath).
-Wash in CTL 3X and plate with 3 U IL-2/ml. Use 3 U IL-2/ml after
removal from freezer of after first stimulation with antigen. The
use 5 U IL-2/ml.
-Stimulate with (24-well flask) 2.6x10_6 APC + 1x10_6 BAT + 10
µg B. burgdorferi/well in 1.5 ml CTL.
PROLIFERATION ASSAY: 1x10_4 BAT/well
1x10_5 APC/well
1 µg B. burgdorferi/well
RELEVANT PROTOCOLS: RBC lysis, mitomycin, MTT, Nylon
Wool Purification.
-Remove 5,000,000 BATs (1 freezing vial).
-Thaw at 37°C (H2O bath).
-Wash in CTL 3X and plate with 3 U IL-2/ml. Use 3 U IL-2/ml after
removal from freezer of after first stimulation with antigen. The
use 5 U IL-2/ml.
-Stimulate with (24-well flask) 2.6x10_6 APC + 1x10_6 BAT + 10
µg B. burgdorferi/well in 1.5 ml CTL.
PROLIFERATION ASSAY: 1x10_4 BAT/well
1x10_5 APC/well
1 µg B. burgdorferi/well
RELEVANT PROTOCOLS: RBC lysis, mitomycin, MTT, Nylon
Wool Purification.
Transfer Buffer (for Western Blot)
2L 3 L 4 L
20 mM Tris Base 4.84 7.3 9.7g
150 mM Glycine 22.52 33.8 45 g
20% Methanol 400 ml 600 ml 800 ml
dH2O 1.6 L 2.4 L 3.2 L
Store @ 4°C.
2L 3 L 4 L
20 mM Tris Base 4.84 7.3 9.7g
150 mM Glycine 22.52 33.8 45 g
20% Methanol 400 ml 600 ml 800 ml
dH2O 1.6 L 2.4 L 3.2 L
Store @ 4°C.
Tris-Glycine Buffer
See Gel Running Buffer
See Gel Running Buffer
| Temp. Conversion C=5/9(F-32) |
TBS (10X) (Tris Buffered Saline)
1L 2 L .
0.15 M NaCl 87.7 175.3 g
0.02 M Tris HCL 31.5 63.0 g
pH to 7.4
For TBS-T (TBS-Tween 20) make 1 X TBS
and make add tween 20 to 0.05% e.g., 1 ml
Tween/2 L TBS.
1L 2 L .
0.15 M NaCl 87.7 175.3 g
0.02 M Tris HCL 31.5 63.0 g
pH to 7.4
For TBS-T (TBS-Tween 20) make 1 X TBS
and make add tween 20 to 0.05% e.g., 1 ml
Tween/2 L TBS.
TAE (50X) (Tris Acetate)
242 g Tris Base
57.1 ml Glacial Acietic Acid
100 ml 0.5 M EDTA
QS to 1 L
242 g Tris Base
57.1 ml Glacial Acietic Acid
100 ml 0.5 M EDTA
QS to 1 L